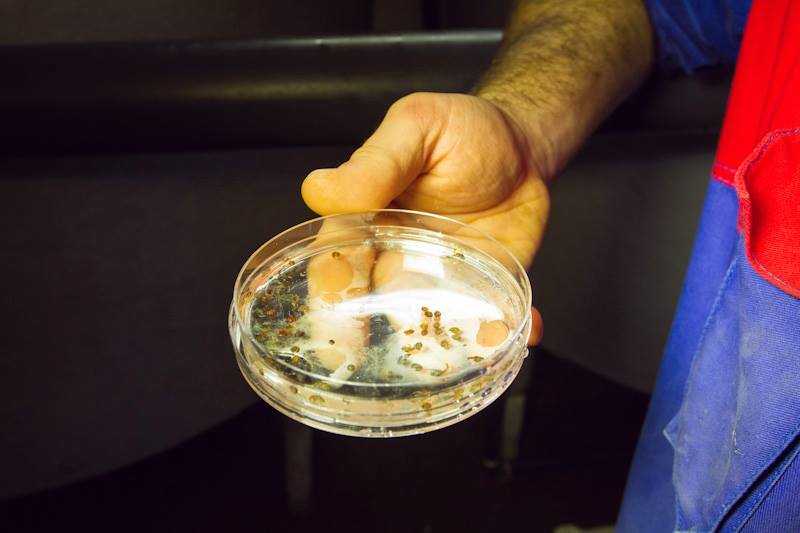

Il progetto si chiama Seasave e come scopo si è fissato quello di ripopolare le acque antistanti il Litorale Nord del Lazio con gli astici.
Il primo lancio è stato effettuato in questi giorni e riguarda circa 30mila avannotti. A operare è il dipartimento di scienze ecologiche e biologiche dell’Università della Tuscia di Viterbo, con la supervisione del professor Giuseppe Nascetti e dalla professoressa Roberta Cimmaruta. Il docente, insieme ai suoi collaboratori, ha iniziato la procedura di ripopolamento per salvaguardare e recuperare la biodiversità marina lungo le coste dell’Alto Lazio, grazie a fondi europei Feamp e della direzione generale della Pesca Acquacoltura del Ministero delle Politiche Agricole, Alimentari e Forestali.